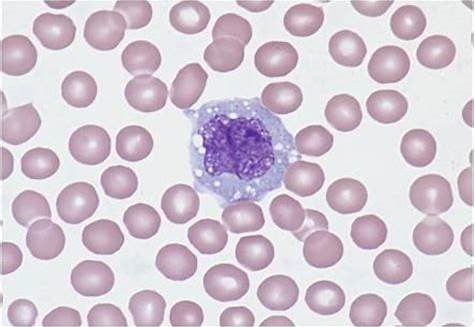

Medical Mystery of the Week
You have recieved your COVID19 immunizations but still participate in Telemedicine.
You are shown a x-ray of the chest and abdomen and a photograph of the oropharynx
(see panels A and B below) of a 19-year-old women whose chief complaints include,
fever, malaise, and sore throat of 7-days duration. You are given no other information.
What is your diagnosis, what test(s) would you order to confirm your suspicions,
and what treatment, if any, do you recommend?
DIAGNOSIS: Epstein-Barr Virus mononucleosis (EBV-MN). EBV is a ubiquitous gamma-herpesvirus
which infects about 95% of the healthy population. This virus is the commonest cause
of infectious mononucleosis, a triad of pharyngitis, lymphadenopathy and fever. Other
less common causes of MN include toxoplasmosis and cytomegalovirus.
EBV seroprevalence increases with age, and tends to be higher in females, non-caucasian
persons, and in lower socioeconomic groups. Clinical manifestations and complications
are lowest when EBV infection occurs in childhood.
EBV has been implicated in a range of hematological malignancies including Burkitt's
lymphoma, nasopharyngeal carcinoma, gastric lymphoma, Hodgkin's lymphoma, and Non-Hodgkin's
lymphoma. EBV infection has been strongly associated with several autoimmune diseases,
particularly multiple sclerosis.
Laboratory studies indicated in patients with suspected EBV-MN include the examination
of the peripheral blood smear for atypical lymphocytes (Downey cells) (see panel C
below) which may be positive (although nonspecific) before seroconversion. White blood
cell counts typically show a relative and absolute lymphocytosis, and the nonspecific
"Monospot" or heterophil test (designed to detect the presence of anti-sheep erythrocyte
antibodies) may become positive within several weeks. Immunofluorescent assays, enzyme
immunoassays, Western blot, and polymerase chain reaction (PCR) assays are also available
to conclude a definitive diagnosis. EBV viral load assays may be useful in patients
with EBV-related diseases.
The treatment of EBV-MN is rest and avoidance of trauma to the spleen. In severe
infections, such as seen in the presented case, the use of corticosteroids may be
indicated.

Panel A. The chest x-ray shows a segmental right lower lobe pneumonia, right-sided
mediastinal and paratracheal adenopathy, and mediastinal rotation and shift to the
right.
Pneumonia, usually segmental and associated with mediastinal adenopathy, occurs in
about 5% of EBV-MN patients.
The abdominal portion of the film shows splenomegaly (note the shift of the
gastric bubble to the right). It is important to remember that enlarged spleens can
rupture with overvigorous palpation; this is particularly true in patients with EBV-MN.
Panel B. The exudative on the patient's tonsils has the characteristic color (yellow to greenish
yellow) of EBV infection; this is in contrast to adenoviral and streptococcal exudates
which, in the experience of the Editor, are white and white-to-grey, respectively.
The patient does not have a Forscheimer's sign (palatal petechiae) which may be seen
in EBV-MN, streptococcal tonsillitis, rubella, rubeola and scarlet fever.
Panel C. An atypical lymphocyte (Downey cell) in a patient with EBV-MN.
Sam Wilson West Parking Lot C...